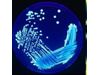

Towertech - Model 1000 -Proportional Timer Controller
The controller has a single timed output suitable for bleed control or dosing of chemicals on many water treatment applications, the output time is adjustable and a override switch with integral red led is mounted on the front of the controller.
The Towertech range of controllers has been designed to give an effective yet simple control of total dissolved solids (TDS) & scale inhibitor dosing on water treatment systems. Both can operate on either proportional basis or alternatively through the internal timer within the PCB circuit.
The controllers have independent time outputs to enable the water treatment system process to be set up to the desired program, the flow meter pulses the controller to the preset pulse count which triggers the first time output (normally bleed valve) on the completion of the preset time the second output time starts the chemical dosing pump until the preset time ceases.
There are two output time modes that can be selected from 0.5 sec’s to 30 minutes giving plenty of flexibility on each output, a water meter LED indication confirms pulses received into the controller and flow through the water system. In the event that a water meter signal isn’t available both controllers can be set to run off the internal timer, therefore setting of the time program is the same only that pulses received count changes to one minute increments.
The controllers are housed in an IP66 polycarbonate enclosure with a clear lid provided as standard.